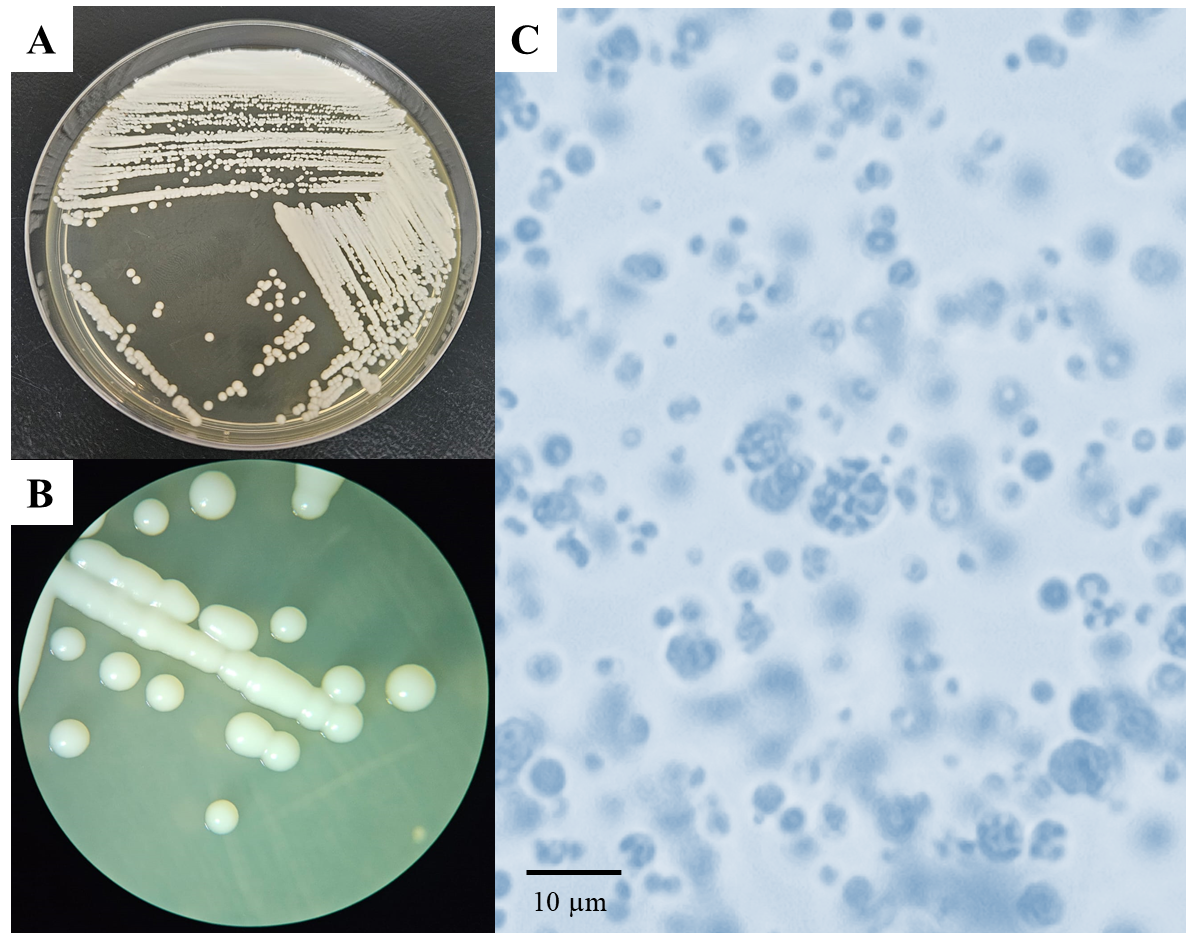
Brazilian Biomes

Sobre o Projeto
Coordenadora
Prof. Dra. Vania Aparecida Vicente
Universidade Federal do Paraná (UFPR)
Linha Temática
VI. Redes de pesquisa para identificação, monitoramento e sequenciamento genético de cepas resistentes em todo o território nacional
Descrição
Este projeto estabelece uma rede para monitoramento e detecção de padrões de resistência antimicrobiana (RAM) em agentes causadores de doenças infecto-parasitárias, preservados em repositórios de coleções de referência e em amostras ambientais de vários biomas brasileiros. Utiliza abordagem metagenômica e sequenciamento NGS, visando o desenvolvimento de um painel amplamente acessível, com aplicação de notificação da circulação de genes e espécies RAM em macrorregiões brasileiras.